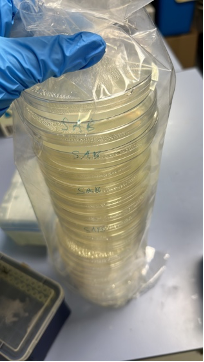

This shouldn’t be that hard right?
That’s what I thought when I was preparing to commence summer 1 research project. After all, I had done research before with the same fungal infections group the summer previous. However, I could not be more wrong!
This is what 20 agar plates look like…
One of the largest challenges I faced was the transition from working with other researchers on someone else’s project to leading this research project alone. In my research experience the summer before, I had worked with Séan Brazil (PhD student in microbiology) on one of his projects. However, this time around, I was leading my own project – which came with several significant challenges. An obvious one being, the workload! Disregarding the fact that I was now running all of my experiments alone (which effectively reduces workforce by half – although I am being quite generous with that figure… Séan has much more lab experience and is much more efficient than I am), I also performed multiple drop dilution assays for the first time, which involves hours of work making 20 toxin- and drug-infused agar plates and even more hours adding conidia onto them (overall, a 3-day process!). Additionally, another challenge was that I had to learn how to be an independent researcher! Not only does this entail designing your own experiments, but it also means analyzing and interpreting your results and tackling issues that arise with your experiments.
Thankfully, I was not thrown directly into the deep end, and still received lots of support from my principal investigator Professor Johannes Wagener and Séan Brazil. Not only were they able to help with their technical knowledge, but they were also great fun to just have a conversation with (working 8 hours in a lab in the basement of a hospital gets lonely sometimes), which made this project very enjoyable.
Furthermore, even though it was tiring, having this experience really helped me gain insight into what it is like to be a scientist. As a medical student, I found being able to really recognize and experience the distinction between a researcher and a physician to be incredibly important. Studying medicine is very clinical – most of the day is spent talking to patients and trying to diagnose and treat them. This is as opposed to being an academic scientist, who spends much of their day in a lab conducting research to further our understanding of science. However, as different as these two occupations sound, we still work hand in hand in combatting disease. Both roles are equally important, and one could not do without the other. As a medical student, having this distinction between both roles will help me greatly in the future when deciding what speciality trainings to apply to, as some specialties are more lab-based while others are almost purely clinical.
Overall, this summer 1 research project was a very positive experience for myself – it was exciting to be leading a project for the first time (although it did come with its challenges) and I managed to find some new potential exciting data that could be explored further down the line. I am incredibly grateful to the Laidlaw Scholarship Foundation for giving me this opportunity.
Please sign in
If you are a registered user on Laidlaw Scholars Network, please sign in